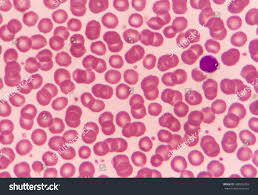
1659 A.D.

-
 The practice of bloodletting began around 2500 B.C. with the Egyptians to try to cure diseases.
The practice of bloodletting began around 2500 B.C. with the Egyptians to try to cure diseases. -
 Greeks distinguished between arteries and veins
Greeks distinguished between arteries and veins
arteries - carry oxygen blood from the heart to various parts of the body
veins - carry deoxygenate towards the body -
Anton van Leeuwenhoek viewed blood cells under a microscope
-
 First blood transfusion performed
First blood transfusion performed -
 Karl Landsteiner discovered three blood types: A,B,O
Karl Landsteiner discovered three blood types: A,B,O -
 Alfred Decastello discovered fourth blood type: AB
Alfred Decastello discovered fourth blood type: AB -
Percy Oliver established the first blood donor service
-
Mayo Clinic developed a method to store blood for transfusions
-
 Dr. Bernard Fantus established the first blood bank
Dr. Bernard Fantus established the first blood bank -
Karl Landsteiner discovered the Rh protein
-
First care of AIDS recorded in the Congo
-
Robert Gallo identified the virus causing AIDS
-
Development of ELISA test to screen diseases such as HIV
-
Scientists began developing blood-screening tests for infectious diseases
A list shows items. A timeline shows sequence.
Use Timetoast to make dates, milestones, and turning points easier to understand in a clear visual format. Timetoast is a timeline maker for work, school, research, and stories.